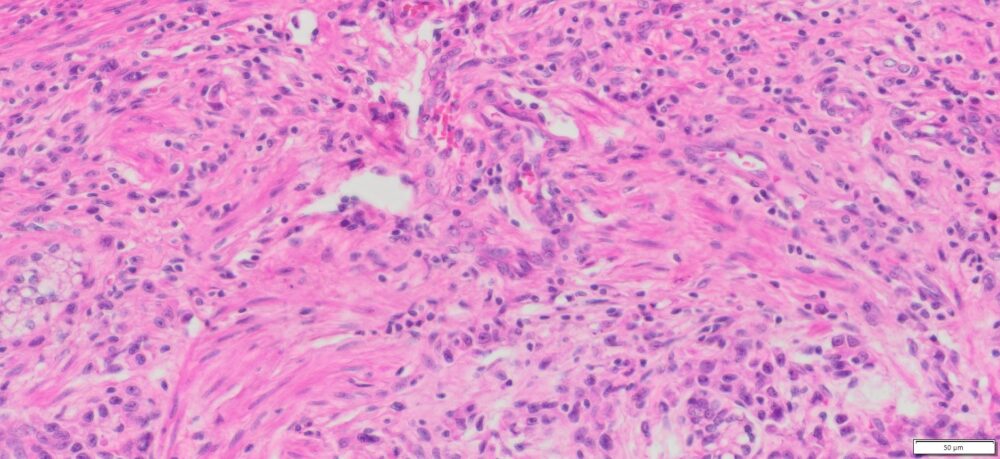
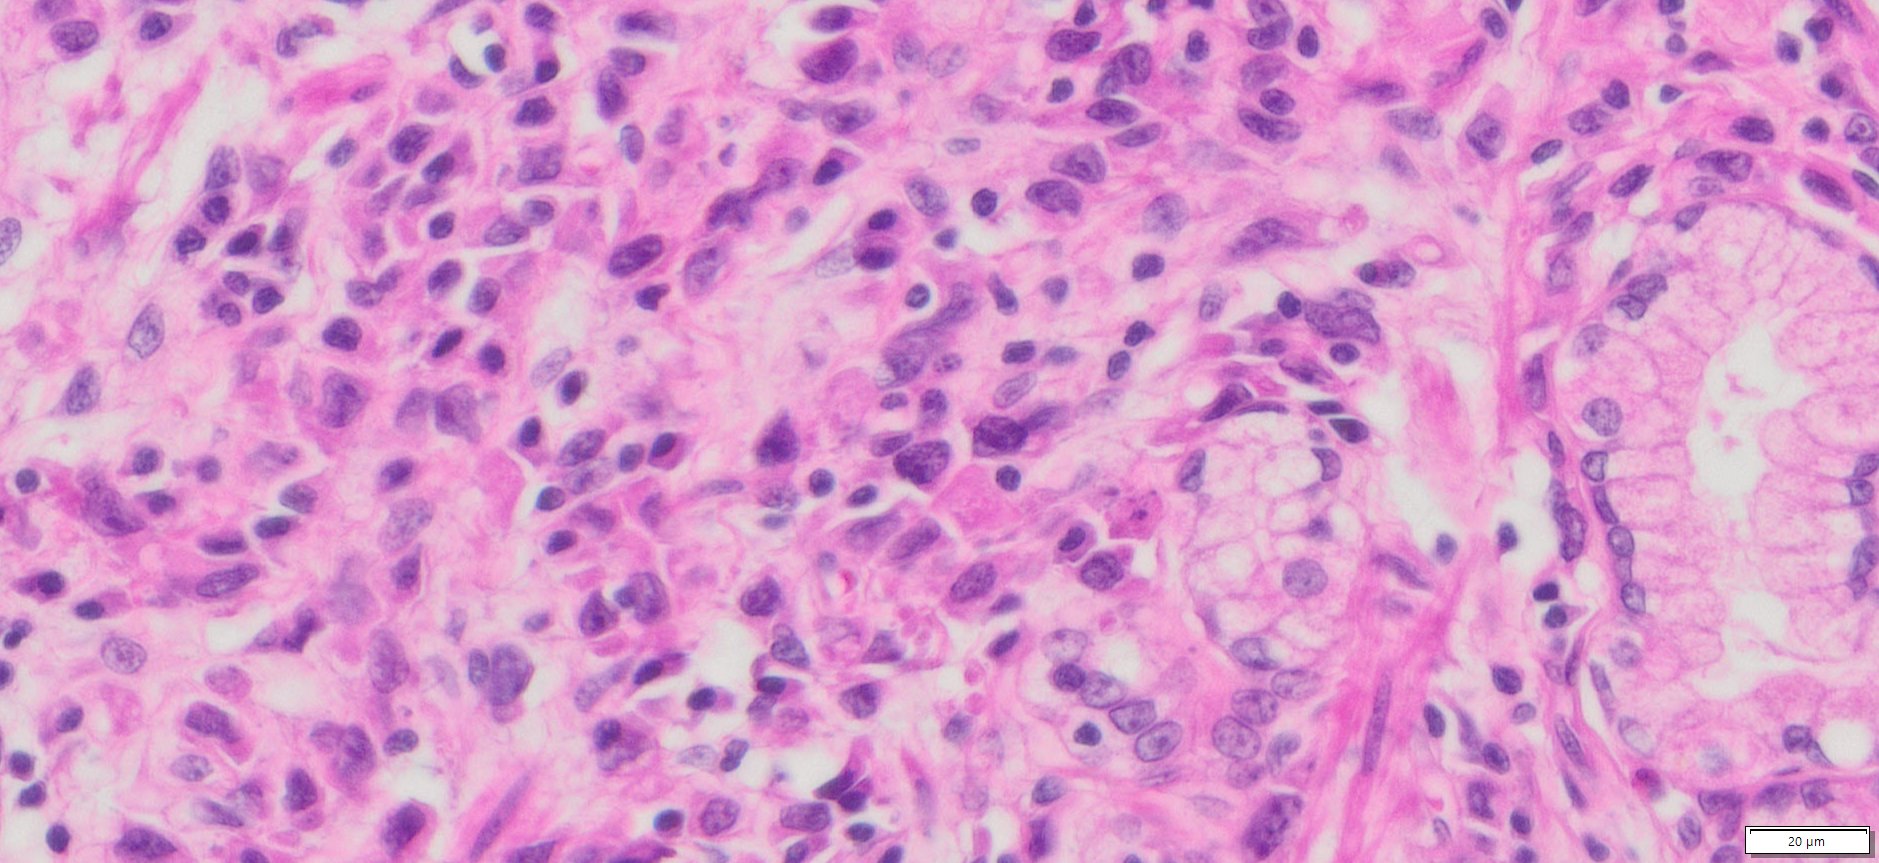

Description
| Organ& Tissue | Pathology Diagnosis | Gender/Age | % Tumor Area | Grade | TMN Stage | Biomarkers |
| Human stomach | Poorly differentiated adenocarcinoma of the stomach, of diffuse type | Female/66 | 15% | III | T2N1M0 |
Slide Preparation
Human tissue was fixed in formalin immediately after excision and embedded in paraffin. The tissue sections were 5 µm in thickness and mounted each on positively charged glass slides.
Sections/slide
1 section on each slide
Slides/Package
5 slides per package
Applications
Histology stain, IHC/IF, FISH and ISH
Storage Condition
Store at 2-8ºC
More Images of H&E Stain and IHC

Product Data Sheet and Material Safety Data Sheet (MSDS) (PDF)